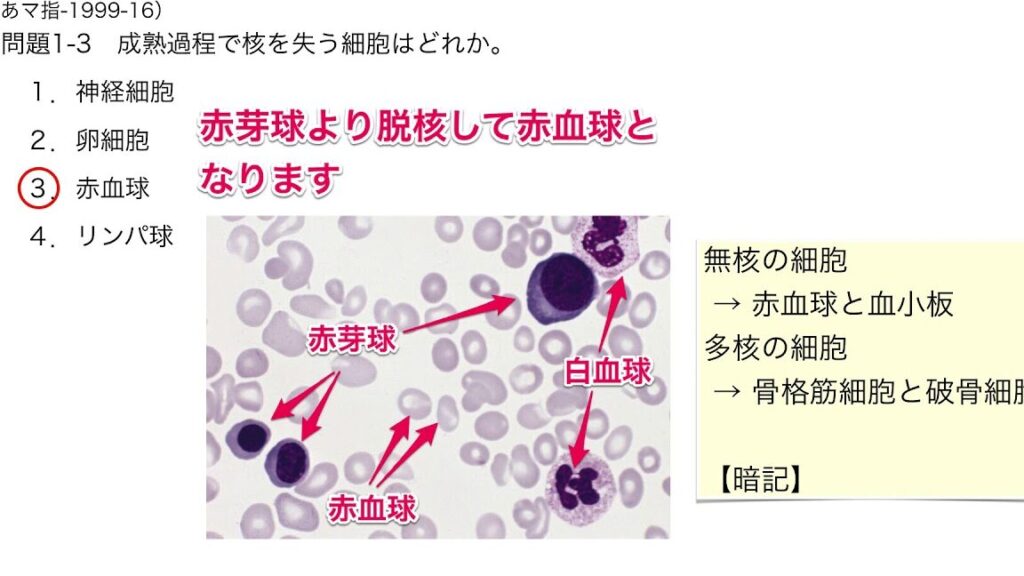

私たちの体を構成する基本単位である細胞の構造と機能は、生命の神秘を解き明かすカギです。細胞は、私たちの健康や成長に不可欠な役割を果たしており、その理解は生物学の基本です。では、細胞のどの部分がどのように機能しているのでしょうか?
細胞の基本構造
細胞は、私たちの体の基本的な単位であり、さまざまな構造がそれぞれ特定の機能を持っています。以下に、細胞の主な構造を説明します。
細胞膜
細胞膜は、細胞の外側を囲む薄い膜です。この膜は、細胞の内部環境を外部から保護します。細胞膜は、選択的透過性を持ち、特定の物質のみが通過できるようになっています。以下は、細胞膜の主な機能です。
- 物質の輸送:細胞内外の物質の移動を調整します。
- 情報の受信:外部からの信号を受け取り、細胞の応答を誘発します。
- 細胞の結合:他の細胞との接触や結合を可能にします。
細胞質
細胞質は、細胞膜と核の間の部分で、細胞のさまざまな構造物が存在します。細胞質の主な成分は以下の通りです。
- 細胞小器官:リボソームやミトコンドリアなど、特定の機能を持つ小さな構造です。
- 細胞骨格:細胞の形を維持し、物質の移動をサポートします。
- 細胞質基質:細胞小器官を含むゲル状の液体成分です。
核
核は、細胞の中心に位置し、遺伝情報を保持する機能を持っています。核の主要な機能には以下があります。
- 遺伝子の保護:DNAを安定した環境で保護します。
- RNAの合成:遺伝情報に基づき、RNAを生成します。
- 細胞周期の調節:細胞分裂の過程をコントロールします。
細胞小器官の機能
細胞小器官は細胞内で特定の機能を果たします。これらの小器官がどのように働くかを理解することで、細胞の複雑な動きが見えてきます。
ミトコンドリア
ミトコンドリアはエネルギーを生産する工場です。細胞呼吸を行い、ATP(アデノシン三リン酸)を合成します。この過程では、酸素を使用してグルコースを分解し、エネルギーを取り出します。多くの細胞には数百から数千のミトコンドリアが含まれており、特に筋肉細胞や神経細胞に多く存在します。
リボソーム
リボソームはタンパク質合成を担う重要な小器官です。細胞質内で、mRNA(メッセンジャーRNA)の情報をもとにアミノ酸を組み合わせてタンパク質を作ります。細胞の種類によって数が異なり、細胞が活発に働くほど多くのリボソームが必要になります。
細胞の種類
細胞は大きく分けて原核細胞と真核細胞の二種類があります。それぞれに独自の特徴と機能があり、生命活動において重要な役割を果たしています。
原核細胞
原核細胞は、核膜を持たない細胞です。そうした細胞の代表例としては、細菌や古細菌が挙げられます。特徴は以下の通りです。
- 核がない: 遺伝情報は細胞質内に浮遊しています。
- 細胞壁を持つ: 多くの原核細胞は細胞壁によって外部から保護されています。
- 小型で単純: 一般的に直径は0.1〜5.0μm程度で、構造が単純です。
原核細胞のシンプルな構造には、迅速な繁殖や環境適応の利点があります。このような細胞は、極限環境での生存能力が高いです。
真核細胞
真核細胞は、明確な核膜を持つ細胞です。動植物、菌類など、多様な生物の基本単位として存在しています。以下の特徴があります。
- 核を持つ: 遺伝情報は核内に格納され、DNAが保護されています。
- 細胞小器官が豊富: ミトコンドリア、リボソーム、ゴルジ体など、多様な細胞小器官が存在します。
- 大型で複雑: 一般的に直径は10〜100μmで、より複雑な構造を持つ細胞です。
細胞の代謝とエネルギー
細胞の代謝は、エネルギー供給を含む生命活動の中心的なプロセスです。細胞はエネルギーを生成し、物質を輸送することによって、機能を維持します。
エネルギー供給
細胞は主にミトコンドリアでATP(アデノシン三リン酸)を生成します。ミトコンドリアは、細胞呼吸を通じて酸素と栄養素を利用し、エネルギーを効率的に生産します。特に、筋肉細胞や神経細胞はエネルギー需要が高く、多くのミトコンドリアを持っています。以下は、エネルギー供給に関する重要なポイントです。
- ミトコンドリアはエネルギー生産の中心。
- ATPは細胞活動のエネルギー源。
- 酸素と栄養素が必要不可欠。
物質の輸送
物質の輸送は、細胞の正常な機能に必要なプロセスです。細胞膜を通じて、栄養素や廃棄物が移動します。この過程では、能動輸送と受動輸送の二つの主要な方法があります。
- 能動輸送:エネルギーを使って、物質を濃度勾配に逆らって移動させます。
- 受動輸送:エネルギーを使わずに、物質が濃度勾配に従って移動します。
結論
細胞の構造と機能を理解することは私たちの健康や生物学への理解を深めるために不可欠です。細胞膜や細胞質、核といった基本的な構造がそれぞれの役割を果たすことで、細胞は生命活動を支えています。特にミトコンドリアやリボソームのような細胞小器官はエネルギー生成やタンパク質合成において重要です。
原核細胞と真核細胞の違いも興味深く、細胞の多様性が生物の適応能力に寄与しています。私たちはこれらの知識をもとに、細胞のさらなる探求を続けていくことが求められます。細胞の理解が進むことで、私たちの健康や生物の未来に新たな道が開かれるでしょう。